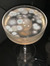

to-read
(460)
currently-reading (17)
read (390)
auto-biography (43)
horror (27)
art (25)
psychology (25)
sci-fi (24)
humor (22)
currently-reading (17)
read (390)
auto-biography (43)
horror (27)
art (25)
psychology (25)
sci-fi (24)
humor (22)
poetry
(21)
enneagram (13)
history (12)
music (11)
dnf (10)
film (10)
chess (9)
gender (9)
philosophy (9)
enneagram (13)
history (12)
music (11)
dnf (10)
film (10)
chess (9)
gender (9)
philosophy (9)

 Goodreads Librarians Group
— 297878 members
— last activity 0 minutes ago
Goodreads Librarians Group
— 297878 members
— last activity 0 minutes ago
Goodreads Librarians are volunteers who help ensure the accuracy of information about books and authors in the Goodreads' catalog. The Goodreads Libra ...more
getting over it’s 2024 Year in Books
Take a look at getting over it’s Year in Books, including some fun facts about their reading.
Favorite Genres
Polls voted on by getting over it
Lists liked by getting over it